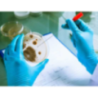
Microbion EX50 Synthetic Polymer Effluent Treatment expert

$695.42
$694.93
-0.07%
World's First Climate Tech Platform | Free Delivery in India | Global Shipping

Shop with confidence knowing that our 24/7 Customer Support is always available to assist with any inquiries

Avail maximum benefits from input tax mechanism on all your Business Invoices. Get GST Invoices on your business purchases. And 0% Taxes on all worldwide deliveries

If you find this product anywhere at lower cost than us. Call us and we will not only match the price but also give a complimentary coupon

Shop with assurance, as each product we offer is 100% original, ensuring quality and authenticity with every purchase
| Type | MICROBION EX50 |
|---|---|
| Applications | Industrial |
| Quantity | As Per customer |
Type:Microbion is a range of bacterial strains that are adapted and immobilized in cereal/mineral based carriers. These strains can then be used in industrial solid waste management and effluent management for effective biological degradation of organic matters. The Microbion range of products are available in aerobic and anaerobic grade bacterial strains and can be specifically adapted for special applications.

Review sent
Your review cannot be sent
Microbion EX50 Synthetic Polymer Effluent Treatment expert
 100% Original & Genuine Products with Manufacturers Warranty
100% Original & Genuine Products with Manufacturers Warranty
 24/7 Customer Support Email/Chat/Telephonic Support
24/7 Customer Support Email/Chat/Telephonic Support
 Fastest Global Shipping Fedex/UPS/DHL/Aramex/BlueDart/Delhivery
Fastest Global Shipping Fedex/UPS/DHL/Aramex/BlueDart/Delhivery
Microbion EX50 Synthetic Polymer Effluent Treatment expert
Comments (0)
Your review appreciation cannot be sent
Report comment
Report sent
Your report cannot be sent